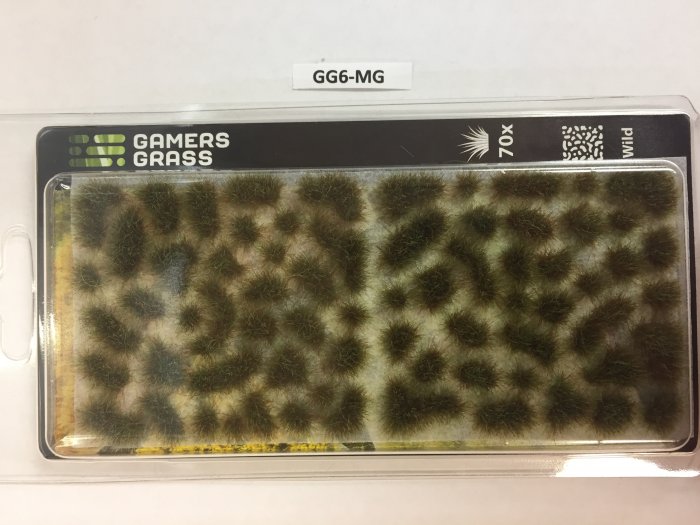
Gamers Grass Mixed Green Tufts

GG6-MG - Gamers Grass Mixed Green Tufts
Mixed green is a dense mixture of different fibre colours to provide a realistic, "woodscape" look.

Terms, Conditions & Product Warning
Mixed green is a dense mixture of different fibre colours to provide a realistic, "woodscape" look.
Terms, Conditions & Product Warning
